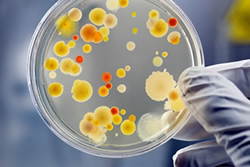

Somos uma empresa que busca superar as expectativas dos nossos clientes, tendo transparência, comprometimento e responsabilidade.Buscamos a cada dia, a melhoria contínua na execução de nossos trabalhos e na relação com nossos clientes.
Nossos profissionais são altamente capacitados na resolução de problemas, com alto conhecimento nas áreas tecnológicas envolvidas, possuindo treinamento no exterior, buscando a cada manutenção superar as expectativas dos nossos clientes. Zelamos a transparência, a integridade e a honestidade em nossos negócios.

Diretor
Técnico especializado em equipamentos para laboratórios
Técnico especializado em equipamentos para laboratórios
Técnico especializado em equipamentos para laboratórios
Assistente Admnistrativo